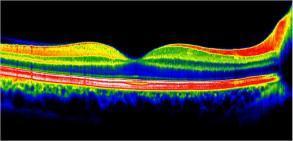
OCT maculaire RNFL nerf optique ganglionnaire

OCT maculaire
Qu'est ce que c'est un OCT de la rétine maculaire ?
L'OCT ou Optical Coherence Tomography est une Tomographie à cohérence optique.
Il permet de dépister les maladies rétiniennes sur la zone centrale de vision nommée macula : un œdème de la rétine, des néovaisseaux, une atrophie, une membrane épi-rétinienne, un trou maculaire, une atteinte de la DMLA, du diabète, ou encore les conséquences d'une occlusion veineuse...
L’image est obtenue par l'émission d'un faisceau laser de faible énergie réalisant des images représentant des coupes des différentes couches de la rétine.
Que faire avant l'examen ?
Il sera nécessaire d'instiller des gouttes dans vos yeux une heure avant, afin de dilater les pupilles.
Il sera donc nécessaire de venir accompagné, car la vision sera floue pendant quelques heures.
Comment se déroule l'examen ?
L'OCT est réalisé sans contact avec l'œil et il est totalement indolore.
L'examen dure moins de quinze minutes.
Que faire après l'examen ?
Avec la dilatation de votre pupille, vous ressentirez une gêne visuelle et un éblouissement durant quelques heures.
Dans ce cas, vous ne pourrez pas conduire immédiatement et il est conseillé de repartir accompagné.